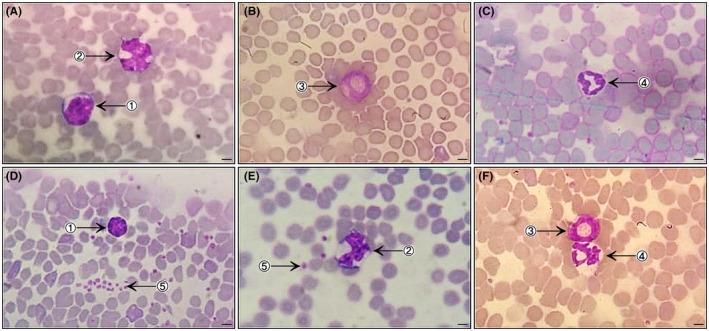
https://cdn.ncbi.nlm.nih.gov/pmc/blobs/7638/7824965/82d6d78a123e/AME2-3-304-g001.jpg

瑞士小鼠、BALB/c小鼠、C57BL/6小鼠和B6D2F1小鼠的临床血液学和生化参数
Clinical hematological and biochemical parameters in Swiss, BALB/c, C57BL/6 and B6D2F1 .
作者信息
Silva-Santana Giorgio, Bax Juliet Cunha, Fernandes Débora Cristina Silva, Bacellar Daniela Tendler Leibel, Hooper Cleber, Dias Alexandre Alves Souza Oliveira, Silva Cristina Barbosa, de Souza Aline Moreira, Ramos Simone, Santos Ricardo Alexandre, Pinto Thainara Ramos, Ramão Mariana Antunes, Mattos-Guaraldi Ana Luíza
机构信息
Health Sciences Center Institute of Microbiology Paulo de Góes Federal University of Rio de Janeiro Rio de Janeiro RJ Brazil.
Laboratory of Diphtheria and Corynebacteria of Clinical Relevance Faculty of Medical Sciences University of the State of Rio de Janeiro Rio de Janeiro RJ Brazil.
出版信息
Animal Model Exp Med. 2020 Dec 18;3(4):304-315. doi: 10.1002/ame2.12139. eCollection 2020 Dec.
BACKGROUND
Animal models are widely used in scientific research in order to obtain information from a whole organism under a specific set of experimental conditions. Various lineages of mice have been used to investigate diseases and new therapeutic strategies, and, consequently, hematological and biochemical tests in these laboratory animals are essential to validate scientific studies. Our study seeks to establish reference values for hematological and biochemical parameters of four lineages of mice.
METHODS
We evaluated the hematological and biochemical profiles of 20 males and 20 females from the lineages Swiss (heterogeneous), BALB/c and C57BL/6 (isogenic), and B6D2F1 (hybrid), totaling 160 mice. Analysis were standardized using the systems pocH-100iV ™ for 19 hematological parameters and VITROS 350 for 12 biochemical parameters.
RESULTS
Results are shown as means and standard deviation, grouped by lineage and genre. Comparing the values obtained in this study with the values from previous studies, some variations were detected, which could be explained by differences in methodologies or individual variability.
CONCLUSION
Thus our study shows that knowledge and disclosure of the values of physiological parameters of laboratory animals is necessary, and emphasises the importance of considering variations influenced by gender, lineage and genotype in the choice of the best experimental model.
背景
动物模型在科学研究中被广泛使用,以便在特定的一组实验条件下从整个生物体获取信息。各种品系的小鼠已被用于研究疾病和新的治疗策略,因此,对这些实验动物进行血液学和生化检测对于验证科学研究至关重要。我们的研究旨在建立四种品系小鼠血液学和生化参数的参考值。
方法
我们评估了瑞士品系(异质)、BALB/c和C57BL/6品系(同基因)以及B6D2F1品系(杂交)的20只雄性和20只雌性小鼠的血液学和生化特征,共计160只小鼠。使用pocH-100iV™系统对19项血液学参数进行分析标准化,使用VITROS 350系统对12项生化参数进行分析标准化。
结果
结果以平均值和标准差表示,按品系和性别分组。将本研究中获得的值与先前研究的值进行比较,检测到一些差异,这可能是由方法学差异或个体变异性解释的。
结论
因此,我们的研究表明,了解和公布实验动物生理参数的值是必要的,并强调在选择最佳实验模型时考虑性别、品系和基因型影响的变异的重要性。